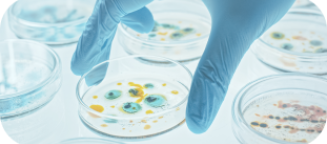
Main gantée tenant un récipient contenant des bactéries.

Conseil scientifique pour le développement de produits de santé innovants
Des produits efficaces, innovants et rentables grâce à une expertise scientifique rigoureuse et pragmatique
En savoir +
Notre expertise
Scineo accompagne les entreprises du secteur de la santé et de la nutrition en innovant et en créant de la valeur au travers d’une approche scientifique robuste et pragmatique.
Les experts Scineo ont une expérience établie et reconnue dans le secteur des soins de santé grand public (OTC) et de l’industrie pharmaceutique et ont participé au lancement et à la valorisation de nombreux produits dans un grand nombre de thématiques de santé.
Scineo accompagne les entreprises du secteur de la santé en leur offrant une expertise scientifique, rigoureuse et pragmatique pour :

Assurer un avantage compétitif au travers de stratégies d'innovation efficaces.

Maîtriser les coûts de R&D en optimisant les processus et en minimisant les risques.

Accélérer la mise sur le marché des produits grâce à des stratégies scientifiques solides.

Renforcer la crédibilité des marques auprès des consommateurs et des professionnels de santé.

Notre approche
Chez Scineo, nous transformons les défis du développement de produits de santé en opportunités. Avec une approche scientifique rigoureuse et pragmatique, nous vous guidons à chaque étape du cycle de vie de vos produits :

Les forces de Scineo
Excellence Scientifique
Connaissance approfondie, expertise et rigueur pour vous assurer une approche scientifique connue et reconnue
Pragmatisme
Nous allions rigueur scientifique et pragmatisme pour assurer la robustesse de vos données tout en contrôlant les coûts et les risques
Valeur Ajoutée
Nos stratégies médico-marketing intégrées augmentent la valeur de vos produits dès leur conception et optimisent votre retour sur investissement
Notre réseau
Leader d’opinions
Scineo s’entoure de KOL internationaux composés de médecins, cliniciens et chercheurs siégeant dans les plus grandes sociétés savantes internationales d’urologie, cardiologie, articulation, phytothérapie et nutrition
Prestataires
Scineo collabore avec un réseau de prestataires qualifiés afin de conduire efficacement vos études cliniques et non cliniques et optimiser vos ressources
Partenaires académiques
Scineo a des liens privilégiés avec des structures de recherche publique (INSERM, CNRS et INRAE) ainsi qu’avec des hôpitaux et universités de renom pour garantir la crédibilité de vos communications scientifiques
Clients
Le portefeuille client de Scineo, composé à la fois de producteurs d’ingrédients, de développeurs, de structures Consumer Health Care et de grands groupes pharmaceutiques permet une mise en relation rapide et efficace des acteurs clés pour le développement de produits et concepts innovants
Prêts à faire avancer vos projets ?
Contactez nous dès aujourd'hui pour découvrir comment Scineo peut vous accompagner dans votre réussite

Réinventons l'accompagnement scientifique pour les entreprises du secteur de la santé.